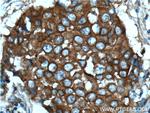
c-SRC Antibody in Immunohistochemistry (Paraffin) (IHC (P))
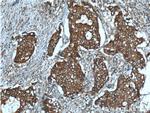
c-SRC Antibody in Immunohistochemistry (Paraffin) (IHC (P))

Search
Proteintech
c-SRC Monoclonal Antibody (5E10C4)
{{$productOrderCtrl.translations['antibody.pdp.commerceCard.promotion.promotions']}}
{{$productOrderCtrl.translations['antibody.pdp.commerceCard.promotion.viewpromo']}}
{{$productOrderCtrl.translations['antibody.pdp.commerceCard.promotion.promocode']}}: {{promo.promoCode}} {{promo.promoTitle}} {{promo.promoDescription}}. {{$productOrderCtrl.translations['antibody.pdp.commerceCard.promotion.learnmore']}}
产品信息
60315-1-IG
种属反应
已发表种属
宿主/亚型
分类
类型
克隆号
抗原
偶联物
形式
浓度
规格
纯化类型
保存液
内含物
保存条件
运输条件
产品详细信息
Immunogen sequence: MGSNKSKPK DASQRRRSLE PAENVHGAGG GAFPASQTPS KPASADGHRG PSAAFAPAAA EPKLFGGFNS SDTVTSPQRA GPLAGGVTTF VALYDYESRT ETDLSFKKGE RLQIVNNTEG DWWLAHSLST GQTGYIPSNY VAPSDSIQAE EWYFGKITRR ESERLLLNAE NPRGTFLVRE SETTKGAYCL SVSDFDNAKG LNVKHYKIRK LDSGGFYITS RTQFNSLQQL VAYYSKHADG LCHRLTTVCP TSKPQTQGLA KDAWEIPRES LRLEVKLGQG CFGEVWMGTW NGTTRVAIKT LKPGTMSPEA FLQEAQVMKK LRHEKLVQLY AVVSEEPIYI VTEYMSKGSL LDFLKGETGK YLRLPQLVDM AAQIASGMAY VERMNYVHRD LRAANILVGE NLVCKVADFG LARLIEDNEY TARQGAKFPI KWTAPEAALY GRFTIKSDVW SFGILLTELT TKGRVPYPGM VNREVLDQVE RGYRMPCPPE CPESLHDLMC QCWRKEPEER PTFEYLQAFL EDYFTSTEPQ YQPGENL (1-536 aa encoded by BC011566)
靶标信息
SRC is a cytoplasmic tyrosine kinase and proto-oncogene involved in the regulation of embryonic development and cell growth. SRC is involved in the regulation of growth and differentiation of eukaryotic cells. SRC associates with the cytoplasmic region of various cell surface receptors to facilitate signal transduction, and is also involved in cytoskeletal organization, cell cycle regulation, and apoptosis. In humans, the gene encoding SRC is present on chromosome 20. Activity of SRC is regulated by two tyrosine residues (Tyr 416 and Tyr527), and phosphorylation of these two sites have opposing effects. Phosphorylation of Tyr416 in the activation loop of the kinase domain upregulates enzyme activity while the phosphorylation of Tyr527 decreases enzyme activity. Mutations in the SRC gene could be involved in the malignant progression of colon cancer. Two transcript variants encoding the same SRC protein have been found thus far.
仅用于科研。不用于诊断过程。未经明确授权不得转售。
生物信息学
蛋白别名: c-Src; EC 2.7.10.2; neuronal proto-oncogene tyrosine-protein kinase Src; OTTHUMP00000174476; OTTHUMP00000174477; OTTHUMP00000174478; p60-Src; pp60c-src; pp60src; Proto-oncogene c-Src; Proto-oncogene tyrosine-protein kinase Src; protooncogene SRC, Rous sarcoma; Rous sarcoma oncogene; RP5-823N20.1; tyrosine kinase pp60c-src; tyrosine protein kinase c-src; tyrosine protein kinase pp60-c-src; tyrosine-protein kinase SRC-1; unnamed protein product; v-src avian sarcoma (Schmidt-Ruppin A-2) viral oncogene homolog; v-src sarcoma (Schmidt-Ruppin A-2) viral oncogene homolog
基因别名: ASV; AW259666; c-SRC; p60-Src; pp60c-src; SRC; SRC1; THC6
UniProt ID: (Human) P12931, (Mouse) P05480, (Rat) Q9WUD9
Entrez Gene ID: (Human) 6714, (Chinese hamster) 100757188, (Mouse) 20779, (Rat) 83805